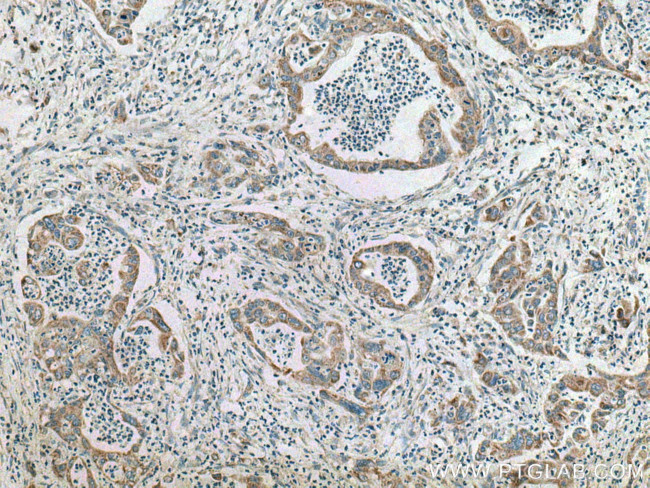
SAPK4 Antibody in Immunohistochemistry (Paraffin) (IHC (P))

Search
Proteintech
SAPK4 Polyclonal Antibody
{{$productOrderCtrl.translations['antibody.pdp.commerceCard.promotion.promotions']}}
{{$productOrderCtrl.translations['antibody.pdp.commerceCard.promotion.viewpromo']}}
{{$productOrderCtrl.translations['antibody.pdp.commerceCard.promotion.promocode']}}: {{promo.promoCode}} {{promo.promoTitle}} {{promo.promoDescription}}. {{$productOrderCtrl.translations['antibody.pdp.commerceCard.promotion.learnmore']}}
产品信息
10217-1-AP
种属反应
已发表种属
宿主/亚型
分类
类型
抗原
偶联物
形式
浓度
规格
纯化类型
保存液
内含物
保存条件
运输条件
产品详细信息
Immunogen sequence: FYLVMPFMQ TDLQKIMGME FSEEKIQYLV YQMLKGLKYI HSAGVVHRDL KPGNLAVNED CELKILDFGL ARHADAEMTG YVVTRWYRAP EVILSWMHYN QTVDIWSVGC IMAEMLTGKT LFKGKDYLDQ LTQILKVTGV PGTEFVQKLN DKAAKSYIQS LPQTPRKDFT QLFPRASPQA ADLLEKMLEL DVDKRLTAAQ ALTHPFFEPF RDPEEETEAQ QPFDDSLEHE KLTVDEWKQH IYK (103-344 aa encoded by BC000433)
靶标信息
MAPK13 (p38 delta) is a serine/threonine kinase that transduces a variety of extracellular signals, including cytokine and environmental stress responses. MAPK13 also regulates the differentiation of keratinocytes. This kinase is activated by various environmental stresses and proinflammatory cytokines. The activation requires its phosphorylation by MAP kinase kinases, or its autophosphorylation triggered by the interaction of MAP3K7IP1/TAB1 protein with this kinase. The substrates of this kinase include transcription regulator ATF2, MEF2C, and MAX, cell cycle regulator CDC25B, and tumor suppressor p53, which suggest the roles of this kinase in stress related transcription and cell cycle regulation, as well as in genotoxic stress response. Four alternatively spliced transcript variants of SAPK4 encoding distinct isoforms have been reported.
仅用于科研。不用于诊断过程。未经明确授权不得转售。
生物信息学
蛋白别名: MAP kinase 13; MAP kinase p38 delta; MAPK13; Mitogen-activated protein kinase 13; Mitogen-activated protein kinase p38 delta; p38-delta MAPK; SAPK4; Stress-activated protein kinase 4
基因别名: MAPK 13; MAPK-13; MAPK13; p38delta; PRKM13; SAPK4
UniProt ID: (Human) O15264
Entrez Gene ID: (Human) 5603